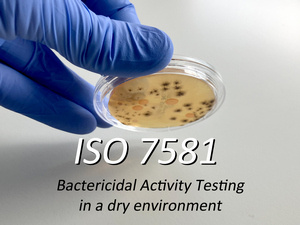

Your competent lab partner for microbiological material testing
Our motivation: Making the world a little safer every day!
Certified products protect our health and prevent infektions
Our lab MTC owns longtime expertise and competence in the fields of molecular biology, genetics, immunology, microbiology, medical engineering, microbiological anmalyses, testing methods and the development of individual setups for new challenges.
The focus of our laboratory is on independent advice, development and implementation of microbiological tests on materials and products of all kinds for the fields of medicine, pharmacy, sanitary, cosmetics, paints, coatings, plastics, technology, consumer goods as well as the microbiological supervision of infection studies.
Microbiological questions are increasingly leading to new challenges due to growing complexity and interdisciplinarity. In addition to the standard methods for evaluating microbial and antimicrobial properties, product and application-specific methods for demonstrating sustainable effectiveness are increasingly required.
Therefore, we develop individual solutions for your microbiological problems on a scientific basis, many years of laboratory experience and established processes.
News from the lab

Skin microbiome tests for animals
Our laboratory has expanded the range of our microbiome tests to include the microbiomes of dogs, cats, horses, cows and rabbits.
In addition, we offer various test methods to demonstrate the effectiveness of products against the pathogens that cause skin infections in animals.
“Die Höhle der Löwen”
Visit from Dr. Jörg Brünke at DS Products GmbH from investor Ralf Dümmel with film footage of the well-known TV show “Die Höhle der Löwen” aired on September 9, 2024 on TV-Channel Vox.
ISO 7581 Test Method
New test method for evaluating the antibacterial effectiveness on surfaces under dry conditions.
“Die Höhle der Löwen”
Visit from Ralf Dümmel in our lab for the famous TV show “Die Höhle der Löwen” aired on April 8th, 2024 on TV-Channel Vox.
ISO 24072 Test Method:
Aerosol bacterial retention test method for air-inlet filter on administration devices
Skin microbiome compatibility test:
Test method for examining the compatibility of personal care products with microorganisms of the skin microbiome
+++ NEW – extended skin protection test – NEW +++
The procedure for investigating the maintenance of skin protection in the presence of cosmetics has been extended and now includes not only an already established skin microbiome system, but also a system that is under development in the presence of the test product.
Vegan skin microbiome test:
Worldwide unique, specially developed animal product-free test method for testing vegan cosmetic products for skin microbiome compatibility
We are happy to face your challenges! Contact us!

We rely on satisfied customers through tested quality –
Our company is certified by TÜV Rheinland.